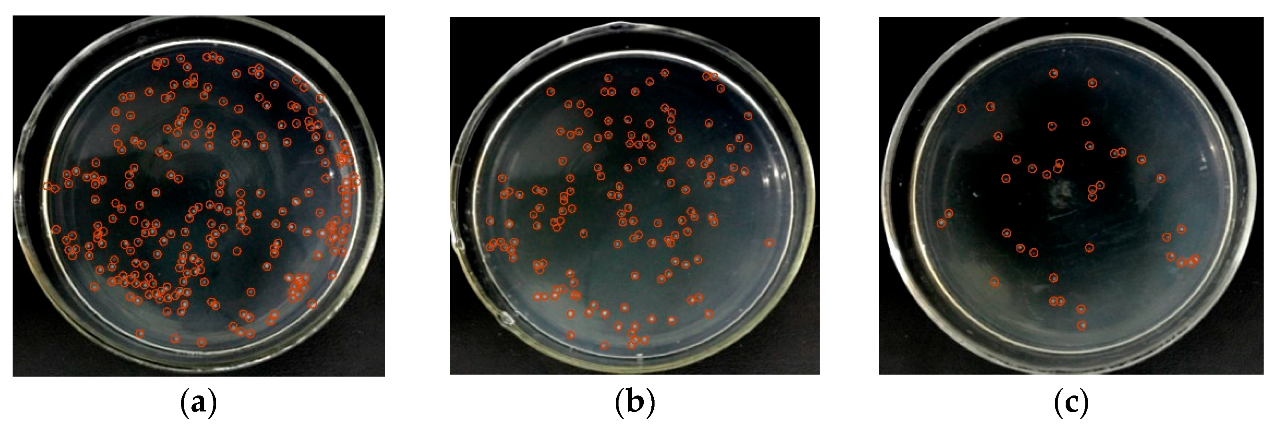
Micromachines 14 00144 g003 Micromachines 14 00144 g003

Electrolysis of Bacteria Based on Microfluidic Technology
Abstract
1. Introduction
2. Materials and Methods
2.1. Theory Background
2.2. Microfluidic Chip Fabrication and Integration
2.3. Experimental Setup
2.4. Sample Preparation
2.5. Statistical Analysis
3. Results
3.1. Bacteria Lysis under Low AC Voltage
3.2. Voltage Effects on the Cell Lysis
3.3. Frequency Effects on the Cell Lysis
3.4. Flow Rate Effects on the Cell Lysis
4. Conclusions
Author Contributions
Funding
Conflicts of Interest
References
- Graham, J.M.; Rickwood, D. Subcellular Fractionation: A Practical Approach; IRL Press: Oxford, UK, 1997. [Google Scholar]
- Islam, M.S.; Aryasomayajula, A.; Selvaganapathy, P.R. A Review on Macroscale and Microscale Cell Lysis Methods. Micromachines 2017, 8, 83. [Google Scholar] [CrossRef]
- Nan, L.; Jiang, Z.; Wei, X. Emerging microfluidic devices for cell lysis: A review. Lab Chip 2014, 14, 1060–1073. [Google Scholar] [CrossRef] [PubMed]
- Pham, V.T.H.; Truong, V.K.; Mainwaring, D.E.; Guo, Y.; Baulin, V.A.; Al Kobaisi, M.; Gervinskas, G.; Juodkazis, S.; Zeng, W.R.; Doran, P.P.; et al. Nanotopography as a trigger for the microscale, autogenous and passive lysis of erythrocytes. J. Mater. Chem. B 2014, 2, 2819–2826. [Google Scholar] [CrossRef] [PubMed]
- Escobedo, C.; Bürgel, S.C.; Kemmerling, S.; Sauter, N.; Braun, T.; Hierlemann, A. On-chip lysis of mammalian cells through a handheld corona device. Lab Chip 2015, 15, 2990–2997. [Google Scholar] [CrossRef] [PubMed]
- Kim, Y.-B.; Park, J.-H.; Chang, W.-J.; Koo, Y.-M.; Kim, E.-K.; Kim, J.-H. Statistical optimization of the lysis agents for Gram-negative bacterial cells in a microfluidic device. Biotechnol. Bioprocess Eng. 2006, 11, 288–292. [Google Scholar] [CrossRef]
- Buser, J.; Zhang, X.; Byrnes, S.; Ladd, P.; Heiniger, E.; Wheeler, M.; Bishop, J.; Englund, J.; Lutz, B.; Weigl, B.; et al. A disposable chemical heater and dry enzyme preparation for lysis and extraction of DNA and RNA from microorganisms. Anal. Methods 2016, 8, 2880–2886. [Google Scholar] [CrossRef]
- Schmidt, M.A.; Jensen, K.F.; Lu, H. A microfluidic electroporation device for cell lysis. Lab Chip 2005, 5, 23–29. [Google Scholar]
- Fang, Y. Dielectrophoretic separation of colorectal cancer cells. Biomicrofluidics 2010, 1, 13204. [Google Scholar]
- Ikeda, N.; Tanaka, N.; Yanagida, Y.; Hatsuzawa, T. On-Chip Single-Cell Lysis for Extracting Intracellular Material. Jpn. J. Appl. Phys. 2007, 46, 6410. [Google Scholar] [CrossRef]
- Ameri, S.K.; Singh, P.K.; Dokmeci, M.R.; Khademhosseini, A.; Xu, Q.; Sonkusale, S.R. All electronic approach for high-throughput cell trapping and lysis with electrical impedance monitoring. Biosens. Bioelectron. 2014, 54, 462–467. [Google Scholar] [CrossRef] [PubMed]
- Jen, C.P.; Amstislavskaya, T.G.; Liu, Y.H.; Hsiao, J.H.; Chen, Y.H. Single-cell electric lysis on an electroosmotic-driven microfluidic chip with arrays of microwells. Sensors 2012, 12, 6967–6977. [Google Scholar] [CrossRef] [PubMed]
- Gabardo, C.M.; Kwong, A.M.; Soleymani, L. Rapidly prototyped multi-scale electrodes to minimize the voltage requirements for bacterial cell lysis. Analyst 2015, 140, 1599–1608. [Google Scholar] [CrossRef] [PubMed]
- Wei, X.Y.; Li, J.H.; Wang, L.; Yang, F. Low-voltage electrical cell lysis using a microfluidic device. Biomed. Microdevices 2019, 21, 22. [Google Scholar] [CrossRef]
- Grahl, T.; Märkl, H. Killing of microorganisms by pulsed electric fields. Appl. Microbiol. Biotechnol. 1996, 45, 148–157. [Google Scholar] [CrossRef] [PubMed]
- Mernier, G.; Piacentini, N.; Braschler, T.; Demierre, N.; Renaud, P. Continuous-flow electrical lysis device with integrated control by dielectrophoretic cell sorting. Lab Chip 2010, 10, 2077–2082. [Google Scholar] [CrossRef]
- Yang, F.; Kuang, C.; Zhao, W.; Wang, G. AC electrokinetic fast mixing in non-parallel microchannels. Chem. Eng. Commun. 2017, 204, 190–197. [Google Scholar] [CrossRef]
- Gao, J.; Yin, X.F.; Fang, Z.L. Integration of single cell injection, cell lysis, separation and detection of intracellular constituents on a microfluidic chip. Lab Chip 2004, 4, 47–52. [Google Scholar] [CrossRef] [PubMed]
- Ameri, S.K.; Singh, P.K.; Sonkusale, S. Utilization of graphene electrode in transparent microwell arrays for high throughput cell trapping and lysis. Biosens. Bioelectron. 2014, 61, 625–630. [Google Scholar] [CrossRef] [PubMed]

Disclaimer/Publisher’s Note: The statements, opinions and data contained in all publications are solely those of the individual author(s) and contributor(s) and not of MDPI and/or the editor(s). MDPI and/or the editor(s) disclaim responsibility for any injury to people or property resulting from any ideas, methods, instructions or products referred to in the content. |
© 2023 by the authors. Licensee MDPI, Basel, Switzerland. This article is an open access article distributed under the terms and conditions of the Creative Commons Attribution (CC BY) license (https://creativecommons.org/licenses/by/4.0/).
Share and Cite
Zhao, J.; Li, N.; Zhou, X.; Yu, Z.; Lan, M.; Chen, S.; Miao, J.; Li, Y.; Li, G.; Yang, F. Electrolysis of Bacteria Based on Microfluidic Technology. Micromachines 2023, 14, 144. https://doi.org/10.3390/mi14010144
Zhao J, Li N, Zhou X, Yu Z, Lan M, Chen S, Miao J, Li Y, Li G, Yang F. Electrolysis of Bacteria Based on Microfluidic Technology. Micromachines. 2023; 14(1):144. https://doi.org/10.3390/mi14010144
Chicago/Turabian StyleZhao, Jianqiu, Na Li, Xinyu Zhou, Zihan Yu, Mei Lan, Siyu Chen, Jiajia Miao, Yulai Li, Guiying Li, and Fang Yang. 2023. "Electrolysis of Bacteria Based on Microfluidic Technology" Micromachines 14, no. 1: 144. https://doi.org/10.3390/mi14010144
APA StyleZhao, J., Li, N., Zhou, X., Yu, Z., Lan, M., Chen, S., Miao, J., Li, Y., Li, G., & Yang, F. (2023). Electrolysis of Bacteria Based on Microfluidic Technology. Micromachines, 14(1), 144. https://doi.org/10.3390/mi14010144





